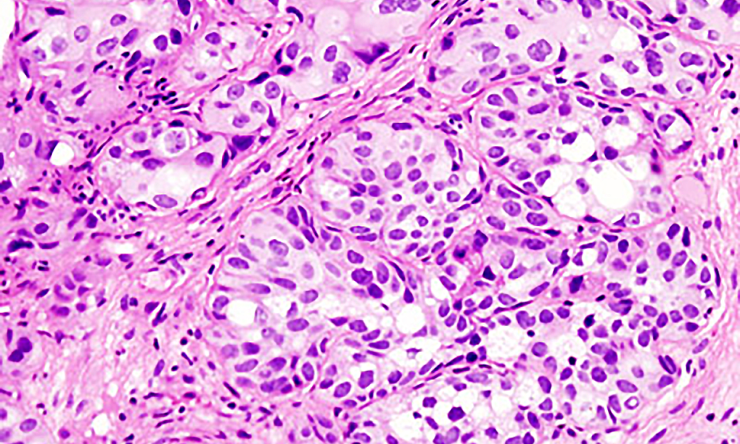
How genomics profiling can help identify the best treatment for bladder cancer

Understanding what makes some bladder cancers resistant to chemotherapy
About one quarter of patients with muscle-invasive bladder cancer (MIBC) may be treated and derive a benefit with the current standard chemotherapy. To better understand why some tumors resist chemotherapy and identify better ways to treat those cancers, researchers at Baylor College of Medicine have conducted a detailed molecular analysis of MIBC tumors. The results, published in Cell Reports Medicine, offer potential new ways to identify which patients will benefit from chemotherapy and reveal possible new treatment strategies.
“One of our goals was to identify molecular markers in patient tumors that would help us predict which patients were most likely to benefit from chemotherapy and which ones might not,” said first co-author, Dr. Matthew V. Holt, director of the Lester and Sue Smith Breast Center Proteomics Laboratory at Baylor.
The researchers studied 60 MIBC tumor samples using a comprehensive multi-omics approach which included genomics (sequencing the genes of the tumor), transcriptomics (analyzing which genes are turned on or off), proteomics (the proteins produced by the tumor) and phosphoproteins (proteins with chemical tags that control their activity).
“By computationally analyzing the vast information generated by the multi-omics approach, we produced a molecular profile for each tumor sample and hoped to uncover patterns linked to resistance to chemotherapy,” said co-first author Dr. Yongchao Dou, assistant professor in the Breast Center at Baylor.
“We were excited about the findings,” Holt said. “For instance, we investigated protein isoforms, which refers to slightly different forms of the same protein, which can behave differently. We found that certain isoforms – especially of proteins like ATAD1 and the RAF family – were more common in tumors that responded well to chemotherapy. These isoforms weren’t detectable by looking at genes or RNA alone, highlighting the importance of studying proteins directly.”
“We also identified molecular pathways linked to resistance,” Dou said. “Wnt signaling, involving a protein called GSK3B, was more active in resistant tumors. The JAK/STAT pathway, especially the protein STAT3, was also more active in resistant cases. These data reveal these pathways as potential therapeutic targets to overcome chemoresistance.”
The study also analyzed proteins targeted by antibody-drug conjugates (ADCs) – a new class of cancer drugs. Proteins like PD-L1, TROP2, and NECTIN-4 were found in different patterns across tumor subtypes. This suggests that combining ADCs with chemotherapy or immunotherapy could be more effective, especially if tailored to the tumor’s subtype.
The researchers also compared the molecular profiles in patients who had both pre- and post-treatment samples and found changes. Some tumors changed their subtype after chemotherapy. They also found that certain proteins involved in cell recycling and energy use were more active after treatment, potentially helping the tumor survive.
“This study identified specific proteins and pathways linked to treatment resistance, as well as potential new ways to treat resistant tumors,” said senior author, Dr. Seth P. Lerner, professor of urology and Beth and Dave Swalm Chair in Urologic Oncology. He also is the director of the Multidisciplinary Bladder Cancer Program at Baylor “This is important because it provides insights that can help expand the population that can be treated effectively and improve overall patient outcomes.”
Other contributors to this work include Meggie N. Young, Alexander B. Saltzman, Meenakshi Anurag, Jonathan T. Lei, Antrix Jain, Mei Leng, Beom-Jun Kim, Lacey E. Dobrolecki, Stefanie F. Faucher, Sara Savage, Chenwei Wang, Zhiao Shi, Hugo Villanueva, Karoline Kremers, Kyle D. Drinnon, Patricia D. Castro, Michael M. Ittmann, Mehak Mehboob Khatani, Sung Han Kim, Matthew J. Ellis, Bing Zhang and Anna Malovannaya, all at Baylor College of Medicine.
This study was supported by Bladder Cancer Advocacy Network Innovation Award, Partnership in Bladder Cancer Research; P30 Cancer Center Support Grant (NCI-CA125123); Dan L. Duncan Comprehensive Cancer Center Award (P30 CA125123), CPRIT Core Facility Awards (RP170005, RP210227, RP220646) and NIH High-End Instrumentation Award (S10 OD026804). Further support was provided by the McNair Medical Institute at the Robert and Janice McNair Foundation and U01CA214125.